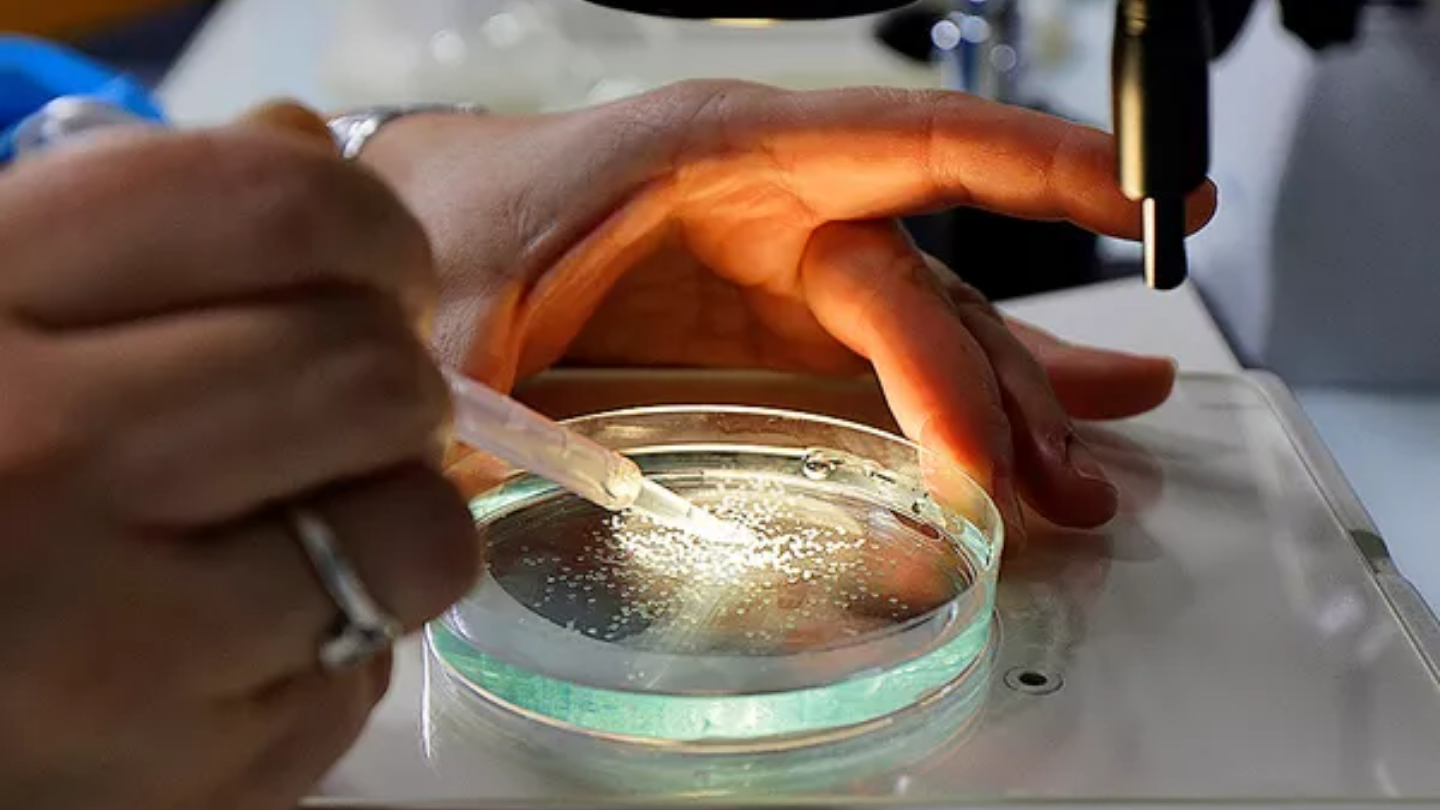

Translational
PhénoParc
Other technologies ?

Translational
LEAT
Animal facility specialized in mouse and zebrafish models, and CRISPR/Cas9 transgenesis.


Translational
PhénoParc
In vivo preclinical functional exploration to validate proofs of concept in accordance with animal ethics.

Translational
Sense organs
Plateformes exploratoires
Preclinical research and innovative models to study vision and validate new therapeutic approaches.

